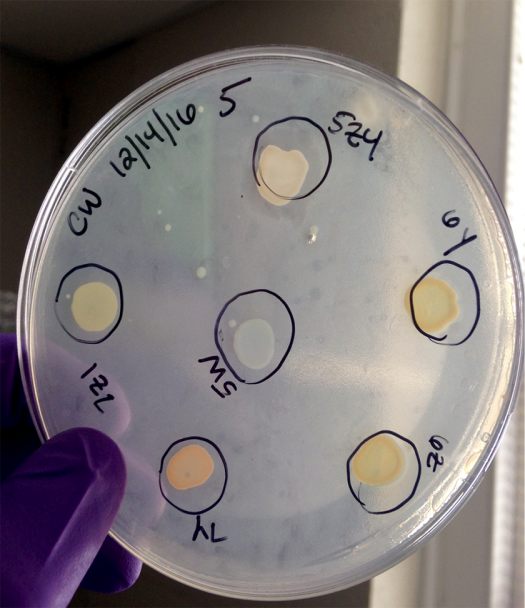
Claire studies bacteria in streams.

High school scientists discover ways to clean the world
Young scientists truly are the harbingers of the future. They are inventing recycled materials, creating alternative water dispensers, working to enact bottle deposit bills, and more.
Spreading the love of science fields and scientific research is one of our main goals at the Society for Science & the Public. As part of that, the Society awarded 20 students competing in science fairs throughout the country, in order to recognize their efforts and STEM work. These Community Innovation Awards, part of the Society’s STEM Action Grants, recognize amazing young scientists.
We spoke with two of these award winners to find out how they first became interested in science, and where they hope to go next. Read on to see why one of them, Monea Floyd, says she’s “just an environmental geek who simply wants to know the theory of everything.”

MONEA FLOYD, LAS VEGAS, NEVADA
WHAT THE COMMUNITY INNOVATION AWARD MEANS TO HER: Being recognized as someone who has sought to innovate and generate eco-friendly alternatives that would reduce our ecological footprint on our planet and induce sustainability within my community is humbling. This achievement continues to inspire me to advocate in climate marches and to contribute to the environmental club at my school.
HOW SHE BECAME INTERESTED IN CLIMATE CHANGE AND THE ENVIRONMENT: It’s challenging for people to acknowledge climate change; however, I’ve always been an environmental nerd. I feel that to understand the purpose of our existence, humanity must realize that our species is a creation by which the artist is Nature. To truly exist, cohesively, we must open their mind to infinity. Mother Earth is whimsical, and facetious, and unpredictable and her story, our story, is what captivates me the most. I aspire to venture to the depths of her unknown and consume all possible knowledge on how to sustain her beauty.
This achievement continues to inspire me to advocate in climate marches and to contribute to the environmental club at my school.
My extraordinary environmental science teacher, Ms. Theriault, encouraged me to participate in the annual Beal Beak Science Fair. I owe all my success and achievements to her. She exemplifies true integrity and is the epitome of existentialism.
Support future young scientists. Join the Society today!
ON THE IMPORTANCE OF SCIENCE FAIRS: Science competitions are an extraordinary opportunity for young adults to collaborate and exchange scientific discoveries with others who retain our same curiosities. It is an opportunity for young adults to build a relationship with the science community, explore concepts and philosophies, challenge their personal capabilities, and create their own conclusions.
HER CURRENT STEM GOALS: My current STEM goals are to develop a clothing brand made entirely of recycled material, enact a bottle deposit bill in Nevada, introduce alternative water dispensers in schools to eliminate the use of plastic containers, and to engulf myself in as many activities that involve bringing environmental awareness.
For anyone seeking to, essentially, change the world, my advice is find your bliss.
HER ADVICE TO OTHERS INTERESTED IN STEM: For anyone seeking to, essentially, change the world, my advice to you is find your bliss. Understand yourself so that others can understand your purpose. Know that the reason you are doing something is for yourself, either to benefit yourself, to learn from yourself, or to experience different parts of yourself. When you do things for yourself, you realize it’s easier to do things for others. My bliss is reading, listening, and experiencing the many miracles that Nature creates. I’m just an environmental geek who simply wants to know the theory of everything. Science competitions are an extraordinary opportunity for young adults to collaborate and exchange scientific discoveries.

Claire Wayner’s long-term goal is to combine her interests in environmental engineering with politics. She wants to pass stronger policies to keep the environment cleaner.
Still in high school, she’s well on her way. Learn more about Claire’s work with a Johns Hopkins University lab to study ways to decrease bacteria like E Coli. in stormwater filtration systems.
CLAIRE WAYNER, BALTIMORE, MARYLAND
WHAT THE COMMUNITY INNOVATION AWARD MEANS TO HER: I am honored to receive this recognition because it validates my project as having a real-world impact in both my local neighborhood and in the international research community. One of my top requirements for my research was that it would have a meaningful effect on my surroundings, including areas not traditionally oriented toward STEM research and education. Researching environmental pollution seemed like a natural fit, and I hope that my results and the broader results of my fellow lab members continue to inform wise stormwater management practices. Having the Society recognize my work like this confirms in my mind that my research is essential to understanding environmental processes further and that cleaning up pollution is a priority for community safety and human public health.
Ask for subscriptions to research journals for your birthday, or pay for them with your own savings!
I would like to thank the Society for Science and the Public for sponsoring this and other awards for student leaders in STEM research. You all are making an informed future a reality, and I look forward to competing in future science fairs and staying connected with the Society.
My research is essential to understanding environmental processes further.
ON RESEARCHING STORMWATER FILTRATION SYSTEMS: I’ve lived almost my entire life in a Baltimore neighborhood located adjacent to an urban stream, Stony Run, which has shaped my foundations since early childhood. It first was a community play space where I could explore the stream ecosystem with my friends. Then it morphed into a place for scientific inquiry complete with tadpoles, macroinvertebrates, birds, and plant life. As I got more mature, I learned more about the pollution problems that Stony Run struggled from, and I became more involved in clean-up projects along the stream, eventually founding a neighborhood volunteer group to restore Stony Run’s waters and surrounding forests.
For my research project, I naturally turned to addressing the water pollution in Stony Run, and I found the Preheim Lab at Johns Hopkins University in the Department of Environmental Health and Engineering. After reading more into the broader research of the lab and their novel research concepts on bacterial pollution in stormwater filtration systems, I decided it was an excellent fit. I joined the lab in June 2016.
Cleaning up pollution is a priority for community safety and human public health.
Since then, I’ve been working on designing my own project, investigating the role of particular species of bacteria naturally occurring in stormwater aquatic environments in removing Escherichia coli from stormwater. So far, I’ve identified a handful of bacteria species that can inhibit the growth of E. coli, and am now investigating these species’ removal properties further in a model stormwater filtration system that we are building in the lab. I hope that my results can help to inform better design and management of stormwater filtration systems. My long-term goal is to mesh my expertise in STEM with my interest in politics to pass stronger and more effective public policy to keep our environment cleaner.
ON THE IMPORTANCE OF SCIENCE RESEARCH AND COMPETITIONS: I always enjoyed nature and biology since a young age, and in middle school I enrolled in the Ingenuity Project, a STEM magnet program for 6-12 grade. There, I had extensive exposure to a variety of scientific and mathematical topics with wonderful teachers, and I had the opportunity to participate in STEM competitions like Math Counts and Science Bowl.
When it came time to pick a high school, I chose to continue in Ingenuity at my local STEM magnet high school, Baltimore Polytechnic Institute. High school has broadened my understanding of STEM concepts, especially when it comes to engineering; I’ve learned through engaging with our school’s aquaponics and design labs, constructed model bridges, and written computer code. The hallmark of my STEM experience culminated in the Ingenuity Project’s Research Practicum, a three-year program that teaches students about the research experience before placing students in 15-month internships in local labs for school credit. Through the research practicum, I have had the chance to plan and conduct my original research under the mentorship of my fantastic lab at JHU and the guidance of my research practicum teacher, Mrs. Lisa Fridman, and countless other STEM mentors that Ingenuity has introduced to me along the way.
[In science fairs,] I can connect the research of my peers to my own work and generate ideas for positive societal impact.
Beyond the potential to win prize money and scholarships (very enticing), science fairs and competitions provide excellent opportunities for students like me to improve their research. The fairs are often divided into categories of research like environmental science, medicine, and engineering design, and by presenting my work next to other expert students in my fields, I can connect the research of my peers to my own work and generate ideas for positive societal impact.
The opportunities to network are phenomenal, and the feedback from judges is extremely useful when I attempt to grow my personal skills (e.g., presenting, public speaking, etc.) and my research direction. Without forcing myself to present my research, I would find it all too easy to lose track of my end goal and do research just for the sake of doing research. Science fairs and competitions are entirely worthwhile and beneficial to me as a person and to my field of scientific research.
Without forcing myself to present my research, I would find it all too easy to lose track of my end goal and do research just for the sake of doing research.
HER CURRENT STEM GOALS: My research has inspired me to major in environmental engineering, which combines traditional engineering concepts from diverse fields like civil and chemical engineering with ecological concepts from biology, chemistry, and geology. Environmental engineering is my best fit. I have never been the traditional tinkerer or “machine nerd,” hooked on engineering since early childhood; instead, I prefer the more flexible fields like environmental engineering that combine innovation and life sciences.
While at college, I hope to join groups like Engineers Without Borders. I also want to broaden my spread of expertise by taking classes in environmental politics, history, sustainable energy, and planning/urban design. I would like to get a graduate degree eventually, but I could also see myself going to law school. My long-term goal is to mesh my expertise in STEM with my interest in politics to pass stronger and more effective public policy to keep our environment cleaner.
HER ADVICE TO OTHERS INTERESTED IN STEM: I never realized how many opportunities there are for young people in STEM, so my first recommendation would be to do several Google searches for youth STEM programs. There might be one at your local university or community college or even a summer camp.
As you get older and develop your interests, you can always reach out to professors at local research institutions and ask to do internships in their lab. Or if you want a more academic setting, you can enroll in courses through online colleges or community colleges to deepen your understanding in a STEM field. The best way to develop your interests is to build relationships and have conversations. Humans learn by networking, and science is no exception; it’s a social field.
The best way to develop your [STEM] interests is to build relationships and have conversations. Science is a social field.
Finally, ask for subscriptions to research journals for your birthday, or pay for them with your own savings! You could read more broad journals like Nature or Science or hone in on your particular interests (my personal favorite is Environmental Science and Technology). I was always an avid reader, but I never learned how to read STEM rhetoric until I did my own research. No one is preventing you from reading any of the scientific literature out there. Your local library may also have a subscription to some of these journals, which could help you get access. Bottom line: read about what interests you in STEM, and don’t be afraid to email people and ask questions.Support young scientists. Join the Society today.


